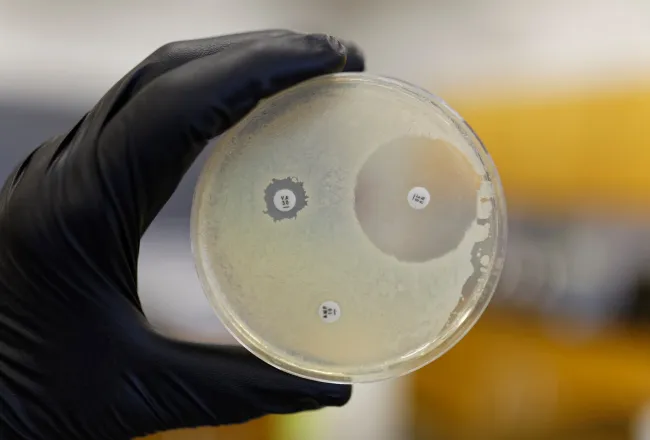
Boîte de Petri montrant la résistance d'une bactérie aux antibiotiques. Boîte de Petri montrant la résistance d'une bactérie aux antibiotiques. -Boîte de Petri montrant la résistance d'une bactérie aux antibiotiques.

- Accueil
- Dernières actualités
- Peptoïdes fluorés, stratégie innovante contre la résistance aux antibiotiques
Peptoïdes fluorés, stratégie innovante contre la résistance aux antibiotiques
Entretien avec Grégory Chaume, lauréat CY Initiative
Le projet porté par Grégory Chaume vise à concevoir et synthétiser des peptoïdes intégrant des briques fluorées, dans l’objectif de développer de nouvelles approches pour lutter contre la résistance aux antibiotiques.
Publiée le
Temps de lecture : 1 minute.
Le projet Émergence FLUOPEPTO, porté par Grégory Chaume, professeur de chimie organique à CY Cergy Paris Université et chercheur au laboratoire BioCIS, explore de nouvelles stratégies pour lutter contre la résistance aux antibiotiques. En combinant les propriétés des peptoïdes, des molécules inspirées des peptides mais plus stables en milieu biologique, et celles du fluor, largement utilisé dans la conception de médicaments, les chercheurs cherchent à élaborer de nouveaux composés susceptibles d’agir contre les bactéries.
Ce projet a pu voir le jour grâce au dispositif de financement CY Initiative, qui soutient l’émergence de nouvelles collaborations et la production de résultats préliminaires nécessaires au développement de projets de recherche d’envergure. Dans un entretien publié sur le site de CY Initiative, Grégory Chaume revient sur son parcours, les objectifs scientifiques de FLUOPEPTO et les étapes clés de ce projet collaboratif, qui pourrait ouvrir la voie à de nouvelles approches thérapeutiques.



